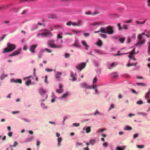

Acral lentiginous melanoma =ميلونوم الشامة المصطبغة على الاطراف
Acral Ientiginous Melanoma
Acral melanoma occurs on the hairless skin of the palms and soles and in the ungual and periungual regions, the soles being the most common site . Acral melanoma is uncommon in all ethnic groups, but it is the predominant form of melanoma in individuals with darker skin. In groups such as Asians, Hispanics, Polynesians, and blacks, in whom the overall incidence of melanoma is low, most melanomas are of the acral type. However, the absolute incidence of acral melanoma in these groups is similar to that in whites, who have a much higher incidence of melanoma overall . These considerations suggest that different etiologic factors, likely not involving sunlight, are operative in acral than in other sites. Although the survival rate of patients with acral melanomas in most series is relatively poor this is likely due to their typically advanced microstage and/or stage at diagnosis. |
Clinically, in situ or microinvasive acral-lentiginous melanoma shows uneven pigmentation with an irregular, often indefinite border. The soles of the feet are most commonly involved. If the tumor is situated in the nail matrix, the nail and nail bed may show a longitudinal pigmented band, and the pigment may extend onto the nail fold (Hutchinson’s sign). Tumorigenic vertical growth may be heralded by the |
onset of a nodule, with development of ulceration . However, some acral melanomas may be deeply invasive while remaining quite flat because the thick stratum corneum seems to act as a barrier to exophytic growth. Histopathology. The lesions are termed lentiginous because the majority of the lesional cells are single and located near the dermal-epidermal junction, especially at the periphery of the lesion . However, usually some tumor cells can be found in the upper layers of the epidermis, especially near areas of invasion in the center of the lesions. The histologic picture differs from that of lentigo maligna because of irregular acanthosis, the lack of elastosis in the dermis, and the frequently dendritic character of the lesional cells . Early in situ or microinvasive lesions may show, especially at the periphery, a deceptively subtle histologic picture consisting of an increase in basal melanocytes and hyperpigmentation with only focal atypia of the melanocytes. However, in the center of the lesions, there is usually readily evident uniform, severe cytologic atypia. There may be a lichenoid lymphocytic infiltrate that may largely obscure the dermal-epidermal junction, and in some cases this may be so dense as to simulate an inflammatory process. In most of the lesions, both spindle shaped and rounded, pagetoid tumor cells are seen, and, in many cases, pigmented dendritic cells are prominent. Pigmentation is often pronounced, resulting in the presence of melanophages in the upper dermis and of large aggregates of melanin in the broad stratum comeum. As in lentigo maligna, when tumorigenic vertical growth phase is present, it is often of the spindle cell type and not uncommonly desmoplastic and/or neurotropic. In |